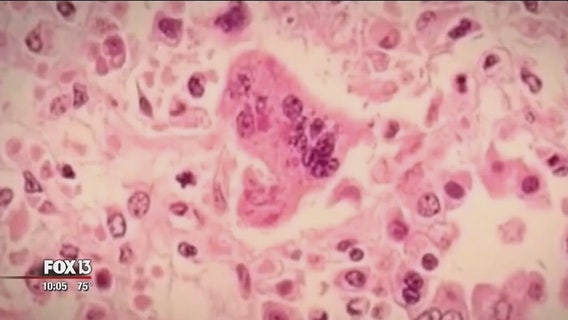
Officials: 4 unvaccinated children have measles in Sarasota County

Special Olympics, Publix raising money to Light the Torch
The 25th annual Special Olympics Florida Torch Campaign is gearing up for its final week and organizers are asking Publix shoppers to help the charity meet its goal.
New year, new tax bracket? Mega Millions jackpot jumps
A lot of people are making their New Year's resolutions. And, for some, that resolution is to is to become a millionaire.
St. Pete councilor hopes negotiations start soon with Rays
The Rays made it official, telling St. Petersburg they are done looking for a new stadium in Hillsborough County.
Bay Area elves read, respond to letters to Santa
As Christmas nears, Santa is so busy he needs a little help opening up all his letters from kids.
K-9 Officer Indi released from vet after shooting
Good news for the police K-9 officer shot in the line of duty this week while searching for the man who fatally shot a DeKalb County Police officer.
Public welcome at St. Petersburg home turned Christmas wonderland
For 42 years, the Kresge family has decked out their house for the holidays and opened it for the public to walk through.
St. Pete to redevelop Tropicana Field property, with or without Rays
As it appears the Tampa Bay Rays will remain in Tropicana Field until 2027, the city of St. Pete says it is still moving forward with a major redevelopment project of that property even if the team isn’t on board.
Rays' plan for Ybor City stadium a no-go
The Tampa Bay Rays' planned move to Ybor City is dead, at least for now.
Officials: 4 unvaccinated children have measles in Sarasota County
Four unvaccinated children have contracted measles in Sarasota County according to health department officials.
Braves' new, high-tech stadium taking shape
Crews are working to beat the clock as the new home of Atlanta Braves spring training takes shape.
Former President George H.W. Bush to lie in state in Capitol Rotunda beginning Monday evening
Former President George H.W. Bush will lie in state in the Capitol Rotunda next week.
Bikes for Christ hopes to deliver to Panhandle kids
When you drive up to Pat Simmon's house, the first thing you notice is bikes - everywhere.
Lacrosse comes to Pinellas schools, but with a catch
The fastest growing high school sport in the country is finally gaining momentum in Pinellas County. Pinellas is the only major county in the Bay Area that doesn't have lacrosse sanctioned in public school.
Hang-gliding passenger holds on for dear life after realizing harness not attached
The video will give you chills. It looks like it can't be real, but for more than two minutes, it was as real as it gets for a Florida man during a tandem hang gliding trip gone wrong.
Forecast: Chilly few nights before weekend warm-up
Tuesday morning was already a chilly one for much of Central Florida, and it’s just the beginning. A freeze watch was been issued for northern parts of the Tampa Bay area ahead of the coldest night yet this fall.
Watch: Fever of rays spotted off Redington Beach
A drone pilot spotted a massive fever of rays just along the shoreline of Redington Beach Thanksgiving morning.
Shoppers scope out deals early for Black Friday
The Thanksgiving turkey hasn't even been carved but people all over the country, and right here in Tampa Bay have been camping out for days in anticipation of Black Friday. And, experts predict this holiday season, Florida shoppers will be spending in record amounts.
Amid E. coli warning, St. Pete farmers provide worry-free romaine
The Center for Disease Control is continuing its warning to stay away from all romaine lettuce as the agency works to trace an E. coli outbreak.
Bay Area restaurants make menu changes amid romaine E. coli warnings
Bay Area restaurant chain Glory Days, with its 10 locations in the Bay Area, is having to make major adjustments to its menu, which has seven items containing romaine lettuce.
Wish kid becomes Tampa Fire Rescue firefighter for a day
An 11-year-old with Cystic Fibrosis had his wish granted Tuesday to become a firefighter.